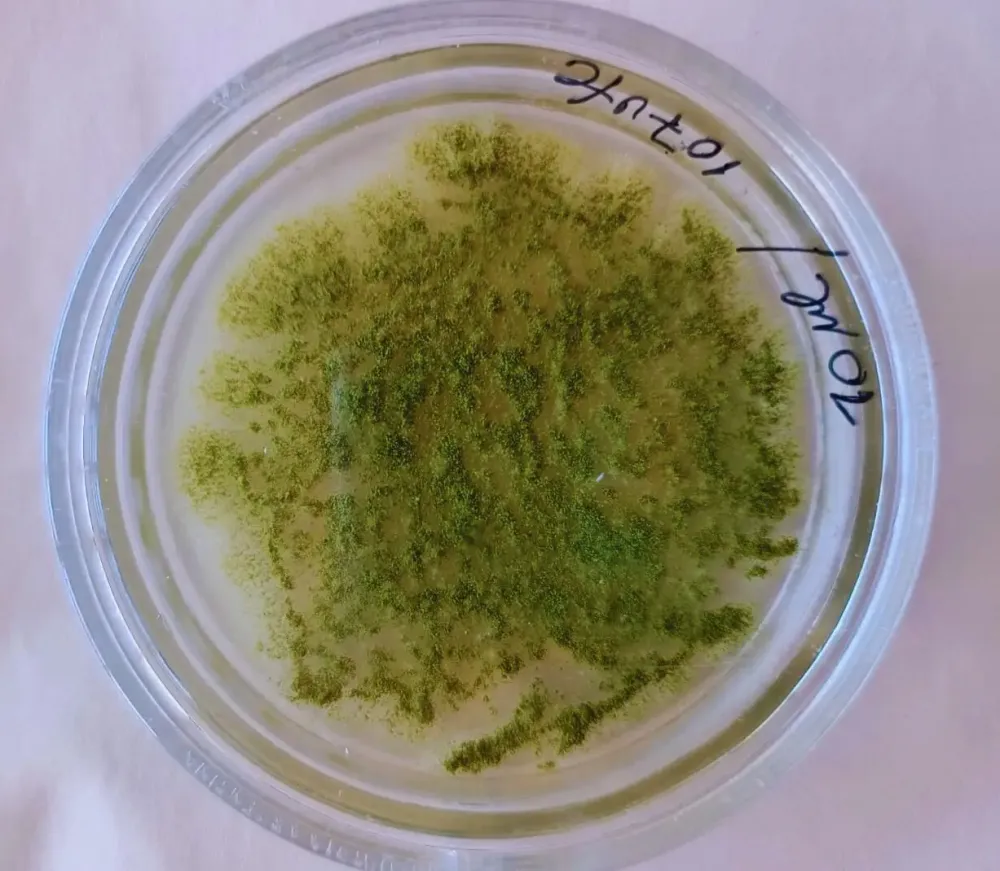

Millones de toneladas de cereales sufren algún tipo de deterioro por la acción de hongos que ocasionan pérdidas de rendimiento y alteraciones en la calidad de los granos, lo que deriva en graves daños económicos. Entre ellos se encuentra Aspergillus flavus, un hongo filamentoso y saprófito, cuya colonización se produce principalmente en granos de cereales y semillas oleaginosas una vez cosechados.
Esta situación llevó a que un equipo de investigadores integrado por especialistas del INTA Instituto de Patobiología Veterinaria, Instituto de Suelos e Instituto de Tecnología de Alimentos, del Instituto de Botánica Darwinion (Conicet/Ancefyn) y de la Facultad de Farmacia y Bioquímica de la UBA, se enfoque en la búsqueda de nuevas alternativas. Así surge el proyecto que propone el desarrollo de un bioinsumo o fungicida natural originado a partir de un extracto de una planta nativa denominada Peltophorum dubium (conocida comúnmente como ibirá pitá).
"Los hongos son organismos ubicuos, son capaces de adaptarse y sobrevivir a situaciones de extrema desventaja", indicó Lucía Di Ciaccio, investigadora del Instituto de Patobiología Veterinaria del INTA-Conicet, quien agregó que el género Aspergillus está presente en el ambiente, en producciones agrícolas y en cultivos y, en condiciones propicias, producen micotoxinas que derivan en enfermedades y en pérdidas económicas.
"El Aspergillus flavus tiene la capacidad de crecer en diferentes sustratos y bajo una amplia gama de condiciones, pero en especial durante el almacenamiento", explicó Renée Fortunato, directora del Instituto Darwinion, quien señaló que los granos, una vez cosechados, contienen una abundante carga de esporas provenientes del campo que se mantienen durante el transporte y en el momento de almacenamiento.
Estrategia de prevención
"Si las condiciones en el almacenamiento no son las adecuadas, se puede producir el deterioro del grano y formarse micotoxinas, como las denominadas aflatoxinas", explicó Fortunato. En esa línea, puntualizó que "estas toxinas son conocidas por su alta toxicidad, tanto para humanos como para animales, ya que pueden causar alteraciones funcionales, bioquímicas o morfológicas".

Por esto, las estrategias de prevención incluyen un estricto control de las condiciones ambientales durante el manejo de la postcosecha y, ocasionalmente, en el uso de sustancias antifúngicas durante períodos críticos en el cultivo y durante el almacenamiento o transporte.
Debido a diferentes factores, solo se dispone de unos pocos agentes antifúngicos, ya sea porque han desarrollado resistencia o por la aparición de hongos llamados reemergentes o también porque son demasiado tóxicos para el huésped y provocan efectos secundarios no deseados. Esta situación llevó a que en las últimas décadas se promuevan diferentes investigaciones destinadas al estudio de extractos de plantas como alternativa para su control.
Así surge el proyecto de investigación del INTA sobre una especie nativa, Peltophorum dubium (nombre común: ibira pitá). El estudio se enfocó en la caracterización de la especie y los extractos vegetales derivados, así como en ensayos de evaluación de los extractos vegetales de Peltophorum dubium para controlar hongos productores de micotoxinas, como el Aspergillus flavus en el almacenamiento de granos de cultivos comerciales como el maíz.
"A través de diferentes estudios, pudimos identificar un extracto vegetal que tenía actividad antifúngica frente a Aspergillus flavus", indicó Di Ciaccio, quien detalló que estudiaron las hojas de este árbol nativo del norte del país, de la familia de las Fabaceae.
"Los datos obtenidos en distintos bioensayos que fueron llevados a cabo de manera in vitro indican que el extracto tiene actividad antifúngica frente a Aspergillus flavus", afirmó la investigadora del INTA, y describió que la actividad es más bien del tipo fungistática, ya que inhibe el crecimiento y desarrollo del hongo y que, además, su sitio de acción es predominante en la pared de las células fúngicas.
Amplios beneficios
Por otra parte, Di Ciaccio señaló: "El extracto vegetal tiene la particularidad de conservar su actividad antifúngica, tanto en el material colectado en la zona donde es nativo (región chaqueña) como en el material de zonas donde ha sido introducido (región pampeana), aunque es mucho más promisoria la detectada en el material de donde es nativa".
Mediante diversas tinciones, se observaron al microscopio óptico cambios en la morfología de las células fúngicas cuando el extracto vegetal está presente, confirmando el efecto. Además, se realizó una caracterización fitoquímica donde se pudo determinar que los flavonoides serían los metabolitos responsables de dicha bioactividad.
"El siguiente paso en la investigación es lograr el desarrollo de un prototipo que pueda ser transferible al sector agroindustrial, en el segmento que se dedica a la postcosecha de granos, área en la cual existe una gran demanda de nuevos productos antifúngicos", agregó la investigadora.

Además, "se propone fomentar el manejo económico, productivo y sustentable del material o recurso vegetal con inclusión social, contemplando a su vez la conservación de las poblaciones del recurso genético silvestre y su hábitat, lo cual otorga valor a la flora nativa del país y el desarrollo regional", puntualizó, por su parte, Fortunato.
De acuerdo con Di Ciaccio, "esta propuesta será transferible al sector agroindustrial con implicancias directas e indirectas de beneficios tanto para la salud humana y animal como para el medioambiente. El producto podrá utilizarse en forma directa y también, sumar actividades (sinergismo) con otros antifúngicos sintéticos existentes en el mercado".